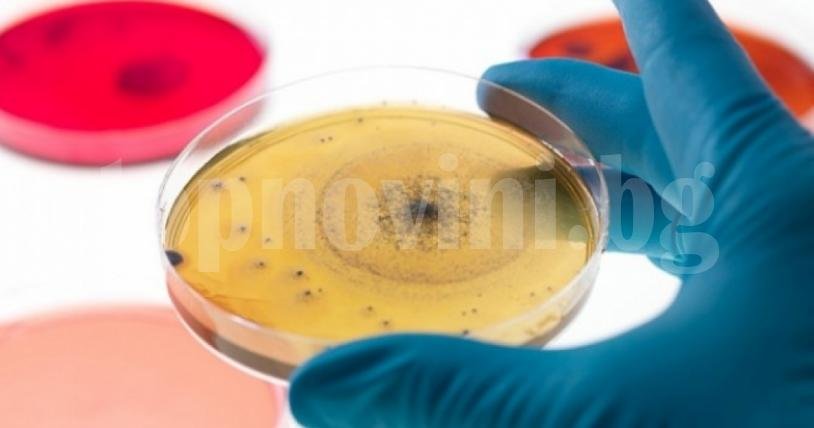
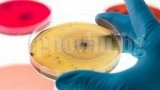

Изследват безплатно за хепатит в Бургас
19:22, 04 юли 16
25
828
Шрифт:
Изследванията ще се проведат на 5 юли (17.00 - 21.00 часа) и 6 юли (09.00 -14.00 часа) до Часовника. Използват се бързи тестове, които работят с капка кръв, а резултатите излизат за 15 мин. Приемът на храна или вода не оказват влияние.
От хепатит В или С страда всеки 12 човек на планетата; това прави 400 млн. души по света. В България няма точна статистика за заболеваемостта, но се предполага, че 110 000 са заразени с вируса на хепатит С, а други 350 000 с вируса на хепатит В. Хепатитът е вирусно заболяване, което поразява основно черния дроб, и ако не се лекува навреме, може да доведе до фатални последици. Най-често симптоми липсват и заболяването може да се установи само чрез кръвен тест.
Последни новини

Отборът на Община Сливен с впечатляващ дебют на XXII Международен спортен фестивал в Албена
18:10, 22 юни 26 / Регионални новини
Скритата азиатска лимонка
19:10, 21 юни 26 / Idealisti
Хладните стандарти: Готова ли е София за 40 градуса?
08:10, 19 юни 26 / Idealisti

Добави коментар